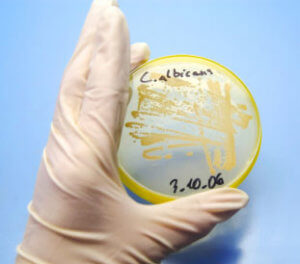

Раннє лікування гінекологічних захворювань, коли хвороба ще не повністю вступила в свої права – запорука успіху і повного одужання.
Атипія шийки матки – це захворювання її слизової оболонки, яке без належного лікування може спровокувати рак. Тобто, клітини слизової матки ще не перетворилися в ракові, але у них є шанси ними стати.
Зміст:
- 1 Чому з’являються атипові клітини шийки матки?
- 2 Які клітини можна вважати атиповими?
- 3 Як виражається атипія шийки матки?
- 4 Методи дослідження атипових клітин шийки матки
- 5 Показання до призначення аналізу
- 6 Розшифровка результатів аналізу
- 7 Профілактика захворювань шийки матки
Чому з’являються атипові клітини шийки матки?
Причин, які можуть спровокувати це захворювання, безліч, тому важливо їх знати, щоб вчасно запобігти розвиток злоякісної пухлини:

Рак шийки матки
Механічні пошкодження матки, травми.Зміни слизової оболонки піхви, які в подальшому переходять на область матки.Процеси ороговіння шийки матки і внутрішніх статевих органів. На медичному мовою таке захворювання називається лейкоплаксией.Ушкодження шийки матки під час пологів або ж під час процедури, де потрібна чистка порожнини матки, в тому числі і аборти.Поранення матки засобами контрацепції типу спіралей і ковпачків, пошкодження її з-за невмілого введення тампона або використання сексуальних іграшок.Порушення в роботі ендокринної системи, гормональні збої і порушення балансу гормонів в організмі жінки.Зараження жінки вірусом папіломи, в тому числі, і в сфері інтимного місця.Заняття безладним сексом, більше ніж з трьома сексуальними партнерами одночасно, або ж секс з партнером, який не зберігає вірність своїй партнерці.Позбавлення невинності занадто рано, в підлітковому віці.Шкідливі звички, а особливо впливає на стан жіночих статевих органів куріння.Слабкий імунітет, з-за якого жінка зазнає серйозних захворювань.Неправильне лікування раніше виникали захворювань статевих органів.Інфекційні захворювання, які передаються статевим шляхом.Увага! Атипові клітини є в тому чи іншому кількості в будь-якому організмі, але якщо він працює правильно і злагоджено, то в цьому немає нічого страшного. Імунна система знищує ці клітини вчасно. Ракові захворювання виникають тільки тоді, коли в цій системі трапляється збій, і атипові клітини не знищуються. Вони мутують і перетворюються в так звані онкологічні. Найстрашніше в тому, що цей процес йде дуже повільно, і людина може зрозуміти те, що він хворий на рак лише через кілька років, коли йому вже не можна допомогти.
Які клітини можна вважати атиповими?
Є ряд ознак, за якими клітку можна віднести до атипових, це такі ознаки, як:

Клітини під мікроскопом
Атипові клітини набагато більше за розміром, ніж клітини нормальні.Клітина поступово починає втрачати свої клітинні ознаки.Порушуються принципи будови клітини.Клітини починають зливатися одна з одною.В організмі хворої людини можна помітити високий вміст ферментів.Структура клітини розпадається, від неї залишається тільки одне ядро, яке починає діяти і існувати самостійно.Сама по собі клітина стає слабкою, можна говорити про те, що вона стає дистрофичной. Стінки клітини поступово розчиняються.У атипової клітці особливо активно розвивається лише вакуолю.Як виражається атипія шийки матки?
Таке захворювання, як і багато інших захворювань гінекологічного характеру, дуже складно розпізнати на ранніх термінах, тому що воно не має ніяких особливих ознак, за яких жінка могла б почати турбуватися. Тільки тоді, коли захворювання переходить у вже досить важку форму, можна помітити відчутні болі внизу живота, і навіть їх жінка може просто не помічати в повсякденній суєті, або ж пояснювати таку біль швидкої менструацією або залишковим явищем після неї.
Часто атипові клітини матки виникають вже на тлі наявного венеричного захворювання, причому це захворювання може бути в будь-якій формі: грибок, вірус, папілома і так далі.
Тому, якщо жінка знає, що у неї вже є захворювання такого характеру, то вона повинна стежити за тим, щоб клітини шийки матки не стали атиповими. Для цього вона повинна спостерігатися у лікаря і регулярно проходити спеціальні тести, які підтверджують або спростовують розвиток таких процесів.
Коли жінка, вже хвора венеричним захворюванням, все ж не встежила за собою і клітини її матки почали мутувати і перетворюватися в атипові, про це можуть свідчити такі ознаки:

Болі
Досить відчутна і неодноразова біль під час статевої близькості.Після застосування тампона можна помітити сторонні кров’янисті виділення з піхви.Дискомфорт в області піхви, який відчувається на протязі всього дня.Свербіж і печіння, турбують жінку. Вони проявляються навіть тоді, коли правила особистої гігієни ретельно дотримуються, а білизна змінюється на чисте і з натуральної тканини.Неприємні запахи з інтимної зони, знову ж таки, навіть якщо жінка регулярно підмивається і змінює білизну.Методи дослідження атипових клітин шийки матки
Перш, ніж говорити про методи дослідження області шийки матки, треба знати, кому і як потрібно проходити ці самі дослідження. Отже, обстеження показано:

Лабораторні дослідження
- всім жінкам, від 30 до 65 років. Досить буде здійснювати один раз в три роки
- дівчатам належить пройти його через три роки після того, як вона почне вести активне статеве життя
- дівчатам, які ще не живуть статевим життям, обстеження потрібно проходити більш часто, один раз в рік
- жінкам, які страждають якими-небудь захворюваннями статевих органів будь-якого характеру, обстеження також потрібно проходити щороку
Дослідження на виявлення атипових клітин шийки матки проводять за допомогою цитології. Для цього з області піхви беруть мазок і відправляють його на лабораторний аналіз.
Якщо цей аналіз показав наявність атипових клітин, то, швидше за все, лікар захоче їх краще розглянути за допомогою спеціального приладу, який називається кольпоскоп. Крім цього, існує аналіз на біопсію. Він передбачає огорожу ділянки слизової, на якому виявлені атипові клітини, і вивчення його з метою встановлення подальшого лікування.
Показання до призначення аналізу
Крім планового обстеження, деяким жінкам можуть призначити аналіз на атипові клітини шийки матки поза чергою. Зазвичай цього служать наступні причини:
Жінка поступила до лікарні з пошкодженням області матки, успішно пішла на поправку і повністю вилікувалася. Через деякий час їй призначають пройти цитологічні дослідження для того, щоб виключити ризик розвитку онкологічного захворювання.

Кандидоз
Тест показаний тим жінкам, у яких виявлено захворювання, що передається статевим шляхом.Після аборту і чищення області матки теж рекомендується додатково пройти всі аналізи.Те ж саме стосується і тих жінок, у яких були важкі пологи, при яких були пошкоджені деякі статеві органи.Часто наполягають на аналізах батьки дівчинки, яка рано втратила цноту, для того, щоб виключити ризик розвитку статевих захворювань і просто механічних пошкоджень статевих органів.Порушення в роботі слизової оболонки. Це може бути і як повна відсутність слизової складової, так і дуже сильне, надмірне виділення слизу з області піхви.Зміни в протіканні менструального циклу, затримки, які не пов’язані з вагітністю.Безплідним жінкам теж потрібно регулярно спостерігатися у гінеколога, так як причиною безпліддя можуть бути серйозні захворювання жіночих органів, у тому числі і ракові.Ерозія слизового покриву шийки матки.Перевірятися не буде зайвим і в тому випадку, якщо жінка довго лікувала яке-небудь захворювання за допомогою гормональної терапії.Насторожитися і звернутися до лікаря з проханням призначити обстеження потрібно і тоді, коли жінка спостерігає за собою сторонні виділення з області піхви, в тому числі і кровянистого характеру. Особливо це повинно насторожити після сексуальних контактів.При плануванні вагітності потрібно здати багато аналізів і пройти тести, в тому числі, і на атипові клітини шийки матки.Жінкам, які часто народжують, 3 і більше разів, теж потрібно стежити за станом своїх статевих органів набагато ретельніше, ніж жінкам не народжували або народжували один раз.Ранні пологи, які відбувалися у віці до 18 років.При частій зміні статевих партнерів.В період клімаксу потрібно відвідувати гінеколога часто і проводити всі необхідні тести, так як в цей період змінюється гормональний фон жінки і відбувається повна перебудова роботи організму.Після і перед установкою контрацепції у вигляді спіралі.Аналізи потрібно здати незаплановано і тоді, коли хтось з близьких родичів по жіночій лінії вже захворів раковим захворюванням жіночих статевих органів, так би мовити, для самозаспокоєння і виключення у себе патології.Розшифровка результатів аналізу
Важливо пам’ятати, що розшифровкою і інтерпретацією результатів повинен займатися тільки лікар. Однак пацієнт повинен знати, що означає та чи інша посліду в аналізі.
Якщо результат негативний, то це означає, що слизова не порушена, і що ніякі патологічні процеси в ній не спостерігаються.
Позитивний результат свідчить про те, що з клітинами матки в порядку не всі, виявлені атипові клітини або інша патогенна мікрофлора. Однак, позитивний тест позитивного тесту ворожнечу, бо хвороба може бути представлена в п’яти стадіях, і це теж вказується в аналізі. Від такої поноси буде залежати подальше лікування жінки і її поведінку.
Стадія 1 говорить про те, що ніяких змін в слизовій матки немає, вона абсолютно здорова.

Гінекологічний кабінет
Стадія 2 вказує, що за допомогою тесту були виявлені деякі клітини, які можна вважати атиповими, але їх кількість настільки мало, що це можна вважати за норму. Для того щоб підстрахуватися і повністю виключити ймовірність захворювання, лікар радить жінці пройти ще кілька аналізів для повного уточнення картини стану її здоров’я.Стадія 3 показує невелике скупчення клітин, показники яких далекі від норми. Це є прямим показником того, що у жінки є ризик розвитку онкологічного захворювання. Якщо в листі аналізу написаний такий результат, то пацієнтці пряма дорога на біопсію з метою уточнення характеру зміни маткового епітелію і встановлення подальшого лікування.Стадія 4 попереджає про те, що аналіз показав деяку кількість клітин, які вже не є атиповими, а точно мутували в ракові. Зазвичай такі клітини набагато більше звичайних, мають значну ядро і велика кількість ядерного вмісту. Якщо проаналізувати стан хромосом, то вони теж мають патологічні зміни. Всі ці показники можуть говорити про початок онкологічного захворювання. Знову ж таки, на результатах одного лише цитологічного дослідження занадто рано і ризиковано робити висновки, тому лікар призначить і повторну цитологію, і ряд інших заходів для більш точної постановки діагнозу.Стадія 5 говорить про те, що в організмі жінки є вже досить значна кількість ракових клітин, і онкологічний процес вже почався. Для того щоб лікуватися далі, жінка буде перенаправлена до онколога, який визначить ступінь ракового захворювання і буде вирішувати, як діяти далі.Увага! Якщо ракові утворення в області шийки матки виявилися у жінки клімактеричного віку, то лікарі не будуть проводити операцію по збереженню цілісності органу, швидше за все, матку просто видалять.
Матка не є життєво важливим органом, а жінка у віці менопаузи вже точно не зможе мати дітей, саме тому лікар не захоче йти на ризик рецидиву захворювання та повністю видалить весь орган.
Профілактика захворювань шийки матки
Як вже зрозуміло з сказаного вище, захворювання шийки матки – це далеко не найприємніше, що може трапитися з жінкою, тому вона може запобігти їх, якщо буде дотримуватися такі правила:
Зведіть кількість своїх сексуальних партнерів до одного. Постарайтеся зберігати йому вірність, того ж вимагайте від свого партнера.

Безпечний секс
Навіть з перевіреним партнером практикуйте лише безпечний секс.Відмовтеся від шкідливих звичок, особливо – від куріння.Більш ніж ретельно дотримуйтесь правил особистої гігієни.Постарайтеся підтримувати свій імунітет в нормі, пийте вітаміни, одягайтеся по погоді.Якщо у Вас є діти, то вчасно проводьте з ними бесіди про сексуальне виховання, розкажіть, що буває, коли підлітки рано позбавляються невинності і мають декілька статевих партнерів. Крім усього цього, варто розповісти про бар’єрної контрацепції, яка єдина у своєму роді допомагає вберегтися від захворювань, які передаються статевим шляхом.Проти ракових захворювань шийки матки існує вакцина, однак, доцільно її використовувати лише тоді, коли у дівчинки почався процес статевого дозрівання, але вона все ще залишається незайманою.Важливо пам’ятати про те, що здоровий спосіб життя – це самий надійний щит від різного роду захворювань, у тому числі й онкологічних.Постарайтеся вчасно відвідувати лікаря і відслідковувати стан свого здоров’я, оскільки є ймовірність того, що хвороба визначиться на ранніх стадіях, і лікарі зможуть Вам допомогти вилікуватися від неї повністю.Таким чином, атипові клітини шийки матки – це ще не хвороба, але їх наявність може привести до самих сумних наслідків, тому дуже важливо спостерігатися у лікаря і дотримуватись всіх заходів профілактики. Пам’ятайте, що атипові клітини є абсолютно в будь-якому організмі, але для того, щоб вони вчасно знищувалися сили організму повинні бути великі, і забезпечувати ці сили – тільки Ваше завдання.